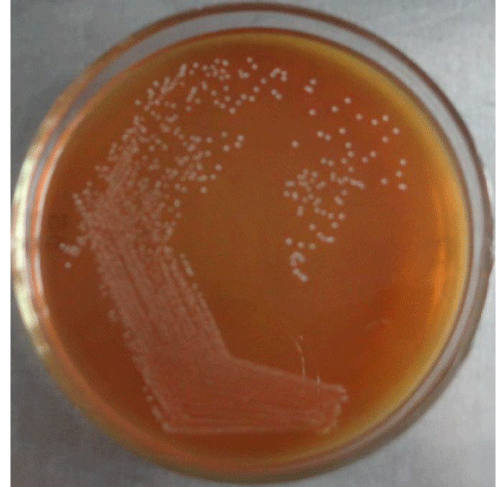

The goal of this study was to use bacteriocin from a probiotic strain of Lactobacillus pentosus S6 (KU92122) to synthesize innovative strong silver nanoparticles (AgNPs)...
Continue reading
The goal of this study was to use bacteriocin from a probiotic strain of Lactobacillus pentosus S6 (KU92122) to synthesize innovative strong silver nanoparticles (AgNPs)...
Continue reading